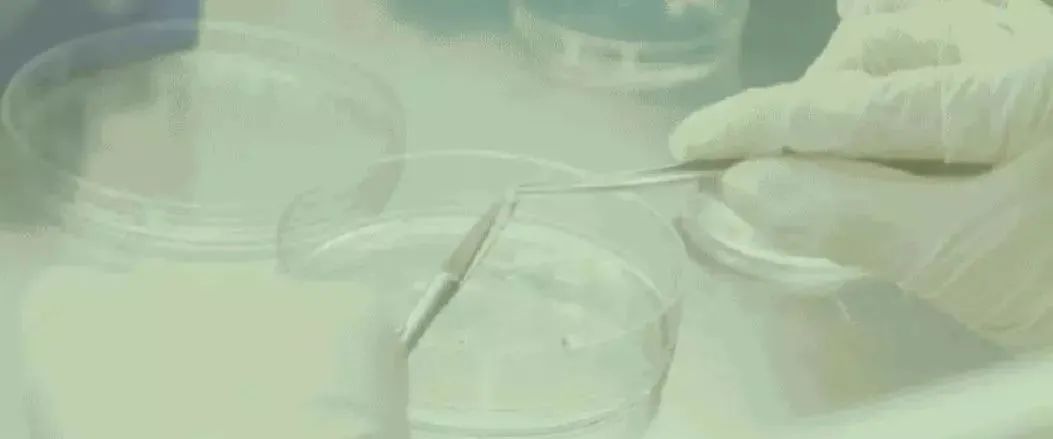
日本医疗,日本体检,日本美容,再生医疗,干细胞,美容,体检,医疗, 日本医疗,日本体检,日本美容,再生医疗,干细胞,美容,体检,医疗,

日本18年18个诺贝尔奖让人叹为观止!尤其在先进医学领域的再生医疗研究和进展,更是世界领先的国家。今天为大家介绍一个再生领域中的新生军,越来越受到重视的“牙髓干细胞”,以及牙髓干细胞的重要临床应用“牙髓干细胞上清液”,了解它是怎样的一种新科技。
牙髓干细胞是什么
牙髓干细胞是从牙齿中提取出来的间充质干细胞,相较其他脂肪干细胞拥有采集方便,无疼痛感的优点。由于其生物活性度也是脂肪干细胞的3倍以上,所以体外培养繁殖速度快,分化成人体多种组织和器官的存活率高,从而更有效地治疗疾病和调节机体免疫力,近年来倍受医学界的青睐。
早期科学家们主要集中在骨髓、脐带血、胎盘等研究干细胞的治疗。2000年代初期美国知名亚裔科学家施松涛教授在做牙齿实验时,首先发现了成年人牙齿中存在干细胞,之后还在儿童乳牙中找到了比成年人牙髓干细胞活性更大,数量更大的牙髓干细胞,并为之取名为“脱落乳牙牙髓干细胞”。
就像人体的器官和组织会渐渐老化一样,组成器官和组织的基础——细胞同样也是有“年龄”的,越年轻的细胞活性就越高,所以不难理解同样是牙髓干细胞,为什么儿童乳牙中的干细胞活性远远高于成人的牙髓干细胞。
日本在研究乳牙牙髓干细胞培养上拥有得天独厚的优势。在我国现在依然保留着“下牙丢到屋顶上,上牙丢到床底下”的换牙习俗的时候,日本已经大规模推广并全民普及了“换牙要去牙科诊所”的生活习惯。
在日本换下的乳牙也可以根据自己的需要由医生登记后保管,所以如果在日本接受“牙髓干细胞”的治疗,更是细致到可以回溯是哪个宝宝的乳牙的培养,从源头保证整个治疗的安全性。
不仅如此,2019年日本大阪牙科大学在《国际分子科学杂志》发表了一篇探讨「牙髓干细胞治疗各种系统性疾病的临床潜力及进展」的报告,深度佐证了牙髓干细胞在再生医疗领域的广阔前景,也再次让世界看到了日本在牙髓干细胞领域研究的一马当先

牙髓干细胞的培养流程
1:取乳牙到实验室
当儿童健康乳牙快掉的时候,牙科医生会将其拔掉,并迅速存放在特质液体中,既保证乳牙不会变质,也可以保持乳牙的活性度。之后乳牙会被运输到培养试验时,准备培养牙髓干细胞。

2:浸泡乳牙提取牙髓干细胞
实验室的技术人员会将送来的乳牙中的牙髓提取出来,并切细成碎块,再放进促进提取牙髓干细胞的“酶”。酶可以帮助牙髓慢慢溶化,使隐藏在牙髓中的干细胞渐渐显现。
3:培养增殖牙髓干细胞
牙髓干细胞显现后,技术人员会将其搜集好后放入培养基中,在培养基中的各种刺激干细胞生长、增殖的物质的作用下(所有的物质的安全性均已通过日本厚生劳动省认证),牙髓干细胞的数量会快速的增长。
4:牙髓干细胞存储
牙髓干细胞的增殖数量满足后首先被装在一种特制的保护液中,之后放在可以承受-196℃的特制存储管中,保证牙髓干细胞迅速进入沉睡状态但不会被“冻死”,之后储存管会放入装着液氮的大罐子里。

5:牙髓干细胞使用
在需要牙髓干细胞进行治疗时,会被取出并恢复到平常温度,苏醒沉睡的牙髓干细胞再次进行“增殖”培养,然后最大限度提取干细胞培养中产生的各种生长因子,只保留上清液用做抗衰治疗使用。

牙髓干细胞上清液通常含有一百多种再生因子并且完全没有排异风险,所以即使是第一次治疗也不需要做配型和验血。相较于脂肪干细胞或脐带血干细胞等点滴回输项目,牙髓干细胞上清液由于完全剥离了干细胞成分,只保留在培养中萃取到的精华部分,所以一次治疗可以投入5倍到15倍干细胞治疗的有效成分。
牙髓干细胞上清液尤其在皮肤组织的修复和新生上效果显著,它可以有效提高肌肤的再生能力,迅速修复受损组织,从皮肤内部精准改善衰老问题。
牙髓干细胞的成熟机构
在日本发展最早也最具代表的牙髓干细胞上清液疗法医院,就是位于东京表参道的深受日本名媛贵妇和达官贵人喜爱的衣理诊所表参道。衣理诊所与日本业界最权威的干细胞培养实验室合作,保证日本制造的高品质传统,并且顾客只需一次赴日并逗留诊所1小时左右,即可完成牙髓干细胞上清液的点滴回输服务。

牙髓干细胞上清液的主要治疗体现在:
☆促进肌肤再生,改善细纹和凹陷

☆治疗头发稀疏、改善脱发现象;

总结:
包括牙髓干细胞上清液在内,目前干细胞越来越多的被证明是有效抗衰和改善慢性病,提高和恢复人体各项机能的新的研究方向。目前通过立法来保证干细胞研究的专业性国家只有美国和日本,尤其是以严谨著称的日本,在相关技术的监管上非常严格,只有经过厚生劳动省认证并颁发许可的机构才可以相关临床治疗。请所有对干细胞在内的再生医疗感兴趣朋友们一定要到专业的机构接受服务。
牙髓干细胞咨询微信:13331189026

<